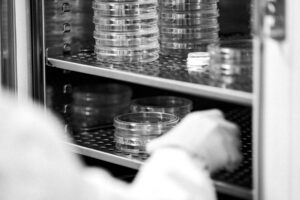

Epidermal Stem Cells in
Health and Disease
Our Mission
In the Mandinova lab we use the epidermis as a model system to study adult stem cells in health and disease. The questions we ask are: How is homeostatic stem cell renewal regulated and how is it balanced with commitment to differentiation to ensure tissue integrity? How does the epidermis withstand and repair frequent injuries and insults? How are genomically damaged stem cells guarded and what permits, in rare cases, aberrant clonal expansion and transformation into benign and malignant lesions? To find our answers, we focus extensively on posttranscriptional regulation of gene expression and its interplay with cellular metabolism. We reason that this approach offers realistic opportunities for therapeutic intervention and identification of “druggable” targets.
Current Projects
Our approach combines numerous experimental approaches, including high-resolution imaging, metabolomics, single-cell or pooled RNA-seq, polysome profiling, TRAP-seq and RIP-seq, organoids, flow cytometry and primary cell culture.
- Identification of essential early events that govern epidermal stem cells differentiation.
- RNA-binding proteins in tumor progression
- Define the age-dependent transcriptional and posttranscriptional changes in metabolism-associated genes for homeostatic skin regeneration
- Adopting a holistic approach to skin biology
Our Team
Join the Lab
Need Copy for this section. Nam liber tempor cum soluta nobis eleifend option congue nihil imperdiet doming id quod mazim placerat facer possim assum. Lorem ipsum dolor sit amet, consectetuer adipiscing elit.